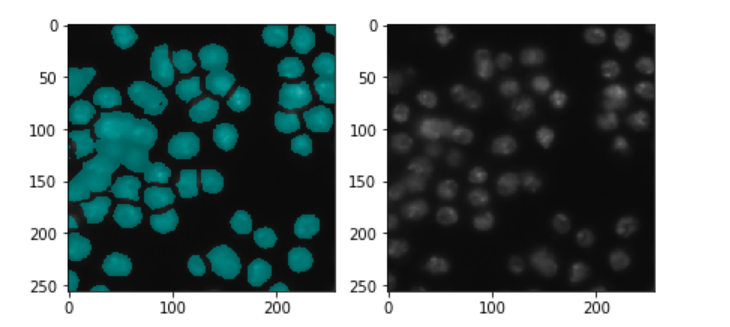

- 原文地址:Semantic Segmentation — U-Net (Part 1)
- 原文作者:Kerem Turgutlu
- 译文出自:掘金翻译计划
- 本文永久链接:github.com/xitu/gold-m…
- 译者:JohnJiangLA
- 校对者:haiyang-tju leviding
写给6个月前的我
我将主要关注语义分割这样一种像素级别的分类任务及其特定的一种算法实现。另外我将提供一些近期一直在做的案例练习。
从定义上讲,语义分割是将图像分割为连续部件的过程。例如,对属于一个人、一辆车、一棵树或数据集里的任何其它实体的每个像素进行分类。
语义分割 VS 实例分割
语义分割相比与它的老哥实例分割来说容易很多。
实例分割中,我们的目标不仅要对每个人,每辆车做出像素级的预测,同时还要将实体区分为 person 1、person 2、tree 1、tree 2、car 1、car 2 等等。目前最优秀的分割算法是 Mask-RCNN:一种使用 RPN(Region Proposal Network)、FPN(Feature Pyramid Network)和 FCN(Fully Convolutional Network)[5, 6, 7, 8] 多子网协作的两阶段方法。

图 4. 语义分割

图 5. 实例分割
研究案例:Data Science Bowl 2018
Data Science Bowl 2018 刚刚结束,在比赛中我学习到很多。其中最重要的一点可能就是,即使有了相较于传统机器学习自动化程度更高的深度学习,预处理与后处理可能才是取得优异成绩的关键。这些都是从业人员需要掌握的重要技能,它们决定了为问题搭建网络结构与模型化的方式。
因为在 Kaggle 上已经有大量对这个任务以及竞赛过程中所用方法的讨论和解释,所以我不会详尽的评述这次竞赛中的每个细节。但由于冠军方案和这篇博文的基础有关联,所以会简要讲解它。
Data Science Bowl 2018 和往届比赛一样都是由 Booz Allen Foundation 组织。今年的任务是在给定的显微镜图像中识别出细胞核,并为其绘制单独的分割遮罩。
现在,先花一两分钟猜下这个任务需要哪种类型的分割:语义还是实体?
这是一个样本遮罩图片和原始显微图像。

图 6. 细胞核遮罩(左)和原始图像(右)
尽管这个任务起初听起来像是个语义分割任务,但其实需要实例分割。我们需要独立地处理图像中的每个核,并将它们识别为 nuclei 1、nuclei 2、nuclei 3 等等,这就类似于前面那个实例中的 Car 1、Car 2、Person 1 等等。也许这项任务的动机是跟踪记录细胞样本中细胞核的大小、数量和特征。这样的自动化跟踪记录过程非常重要,有助于进一步加速各种疾病治疗实验的研究进程。
你现在可能想,如果这篇文章是关于语义分割的,但如果 Data Science Bowl 2018 是实例分割任务样例,那么我为什么一直要讨论这个特定的比赛。如果你在考虑这些,绝对是正确,这次比赛的最终目标并不能作为语义分割的样例。但是,如何将这个实例分割问题转化为多分类的语义分割任务。这是我尝试过的方法,虽然在实践过程中失败了但是也对最后成功有一定帮助。
在这三个月的竞赛中,在整个论坛中分享或至少明确讨论的只有两种模型(或它们的变体):Mask-RCNN 和 U-Net。正如前面所述,Mask-RCNN 是目前最优秀的对象检测算法,它同实例分割中一样能检测出单个对象并预测它们的遮罩。但由于 Mask-RCNN 使用了两阶段的方式,需要先优化一个 RPN(Region Proposal Network)然后同时预测边界框、类别和遮罩,所以部署与训练都会非常困难。
另一方面,U-Net 是种非常流行的用于语义分割的端到端编解码网络[9]。最初它也是创建并应用在生物医学图像分割领域,和这次 Data Science Bowl 非常类似的任务。在这种竞赛中没有银弹,这两种架构如果不做后处理或预处理亦或结构上细微的调整,都不能得到较好的预测值。我在这次比赛中并没有机会尝试 Mask-RCNN,所以我就围绕着 U-Net 进行试验,学习到很多东西。
另外,由于我们的主题是语义分割,Mask-RCNN 就留给其他博客来解释。但如果你想在自己的 CV 应用上尝试它们,这里有两个已实现功能并受欢迎的 github 库:Tensorflow 和 PyTorch。[10, 11]
现在,我们继续讲解 U-Net,并深入研究它的细节...
下面先以它的体系结构开始:

图 7. 原生 U-Net
对于熟悉传统卷积神经网络的朋友来说,第一部分(表示为下降)的结构非常眼熟。第一部分可以称作下降或你可以认为它是编码器部分,你在这里用卷积模块处理,然后再使用最大池化下采样,将输入图像编码为不同层级的特征表示。
网络的第二部分则包括上采样和级联,然后是普通的卷积运算。对于一些读者来说,在 CNN 中使用上采样可能是个新概念,但其思路很简单:扩展特征维度,以达到与左侧的相应级联块的相同大小。这里的灰色和绿色的箭头表示将两个特征映射在一起。与其他 FCN 分割网络相比,U-Net 在这方面的主要贡献在于,在上采样和深入网络过程中,我们将下采样中的高分辨率特征与上采样特征连接起来以便在后续的卷积过程中更好地定位和学习实体的表征。由于上采样是稀疏操作,我们需要在早期处理过程中获取良好的先验,以更好的表示位置信息。在 FPN(Feature Pyramidal Networks) 中也有类似的连接匹配分级的思路。

图 7. 原生 U-Net 张量图解
我们可以将在下降部分中的一个操作模块定义为“卷积 → 下采样”。
# 一个采样下降模块
def make_conv_bn_relu(in_channels, out_channels, kernel_size=3, stride=1, padding=1):
return [
nn.Conv2d(in_channels, out_channels, kernel_size=kernel_size, stride=stride, padding=padding, bias=False),
nn.BatchNorm2d(out_channels),
nn.ReLU(inplace=True)
]
self.down1 = nn.Sequential(
*make_conv_bn_relu(in_channels, 64, kernel_size=3, stride=1, padding=1 ),
*make_conv_bn_relu(64, 64, kernel_size=3, stride=1, padding=1 ),
)
# 卷积然后最大池化
down1 = self.down1(x)
out1 = F.max_pool2d(down1, kernel_size=2, stride=2)
U-Net 下采样模块
同样我们可以在上升部分中定义一个操作模块:“上采样 → 级联 → 卷积”。
# 一个采样上升模块
def make_conv_bn_relu(in_channels, out_channels, kernel_size=3, stride=1, padding=1):
return [
nn.Conv2d(in_channels, out_channels, kernel_size=kernel_size, stride=stride, padding=padding, bias=False),
nn.BatchNorm2d(out_channels),
nn.ReLU(inplace=True)
]
self.up4 = nn.Sequential(
*make_conv_bn_relu(128,64, kernel_size=3, stride=1, padding=1 ),
*make_conv_bn_relu(64,64, kernel_size=3, stride=1, padding=1 )
)
self.final_conv = nn.Conv2d(32, num_classes, kernel_size=1, stride=1, padding=0 )
# 对 out_last 上采样,并与 down1 级联,然后卷积
out = F.upsample(out_last, scale_factor=2, mode='bilinear')
out = torch.cat([down1, out], 1)
out = self.up4(out)
# 用于最后预测的 1 * 1 卷积
final_out = self.final_conv(out)
U-Net 上采样模块
仔细看下结构图,你会发现输出尺寸(388 * 388)与原始输入(572 * 572)并不一致。如果你希望输出保持一致的尺寸,你可以使用填充卷积来保持跨级联的维度一致,就像我们在上面的示例代码中所做的那样。
当提到这种上采样时,您可能会遇到以下术语之一:转置卷积、上卷积、反卷积或上采样。很多人,包括我在内的很多人以及PyTorch技术文档都不喜欢反卷积这个术语,因为在上采样阶段,我们实际上是在做常规的卷积运算,并没有字面上所谓的“反”。在进一步讨论之前,如果你不熟悉基本卷积运算及其算术,我强烈建议你访问查看here.。[12]
我将解释从简单到复杂的上采样方法。这里有三种在 PyTorch 中对二维张量进行上采样的方法:
最近邻插值
这是在将张量调整(转换)为更大张量(例如2x2到4x4、5x5或6x6)时寻找缺失像素值的最简单方法。
我们使用 Numpy 逐步实现这个基础的计算机视觉算法:
def nn_interpolate(A, new_size):
"""
逐步实现最近邻插值
"""
# 获取大小
old_size = A.shape
# 计算扩充后的行与列
row_ratio, col_ratio = new_size[0]/old_size[0], new_size[1]/old_size[1]
# 定义新的行与列位置
new_row_positions = np.array(range(new_size[0]))+1
new_col_positions = np.array(range(new_size[1]))+1
# 按照比例标准化新行与列的位置
new_row_positions = new_row_positions / row_ratio
new_col_positions = new_col_positions / col_ratio
# 对新行与列位置应用 ceil (计算大于等于该值的最小整数)
new_row_positions = np.ceil(new_row_positions)
new_col_positions = np.ceil(new_col_positions)
# 计算各点需要重复的次数
row_repeats = np.array(list(Counter(new_row_positions).values()))
col_repeats = np.array(list(Counter(new_col_positions).values()))
# 在矩阵的各列执行列向插值
row_matrix = np.dstack([np.repeat(A[:, i], row_repeats)
for i in range(old_size[1])])[0]
# 在矩阵的各列执行列向插值
nrow, ncol = row_matrix.shape
final_matrix = np.stack([np.repeat(row_matrix[i, :], col_repeats)
for i in range(nrow)])
return final_matrix
def nn_interpolate(A, new_size):
""向量化最近邻插值"""
old_size = A.shape
row_ratio, col_ratio = np.array(new_size)/np.array(old_size)
# 行向插值
row_idx = (np.ceil(range(1, 1 + int(old_size[0]*row_ratio))/row_ratio) - 1).astype(int)
# 列向插值
col_idx = (np.ceil(range(1, 1 + int(old_size[1]*col_ratio))/col_ratio) - 1).astype(int)
final_matrix = A[:, row_idx][col_idx, :]
return final_matrix

[PyTorch] F.upsample(…, mode = “nearest”)
>>> input = torch.arange(1, 5).view(1, 1, 2, 2)
>>> input
(0 ,0 ,.,.) =
1 2
3 4
[torch.FloatTensor of size (1,1,2,2)]
>>> m = nn.Upsample(scale_factor=2, mode='nearest')
>>> m(input)
(0 ,0 ,.,.) =
1 1 2 2
1 1 2 2
3 3 4 4
3 3 4 4
[torch.FloatTensor of size (1,1,4,4)]
双线性插值
双线性插值虽然计算效率不如最近邻插值,但它是一种更精确的近似算法。单个像素值被计算为基于距离的所有其它像素值的加权平均值。
[PyTorch] F.upsample(…, mode = “bilinear”)
>>> input = torch.arange(1, 5).view(1, 1, 2, 2)
>>> input
(0 ,0 ,.,.) =
1 2
3 4
[torch.FloatTensor of size (1,1,2,2)]
>>> m = nn.Upsample(scale_factor=2, mode='bilinear')
>>> m(input)
(0 ,0 ,.,.) =
1.0000 1.2500 1.7500 2.0000
1.5000 1.7500 2.2500 2.5000
2.5000 2.7500 3.2500 3.5000
3.0000 3.2500 3.7500 4.0000
[torch.FloatTensor of size (1,1,4,4)]
转置卷积
在转置卷积中,我们可以通过反向传播来学习权重。在论文中,我尝试了针对各种情况的所有上采样方法,在实践中,你可能会更改网络的体系结构,可以尝试所有这些方法,以找到最适合问题的方法。我个人更喜欢转置卷积,因为它更可控,但你可以直接使用简单的双线性插值或最近邻插值。
[PyTorch] nn.ConvTranspose2D(…, stride=…, padding=…)

图 8. 使用不同参数的转置卷积样例,转自 github.com/vdumoulin/c… [12]
在这个 Data Science Bowl 的具体案例中,使用原生 U-Net 的主要缺点就是细胞核的重叠。如前图所示,创建一个二元的遮罩作为目标输出,U-Net 能够准确做出类似的预测遮罩,这样重叠或邻近的细胞核就会产生联合在一起的遮罩。
Fig 9. 重叠的细胞核遮罩
对于实例重叠问题,U-Net 论文的作者使用加权交叉熵来着重细胞边界的学习。这种方法有助于分离重叠的实例。基本思路是对边界进行更多的加权操作以使网络能够学习相邻实例间的间隔。

图 10. 加权映射

图 11. (a)原图 (b)各实例添加不同底色 (c)生成分割遮罩 (d)像素加权映射
解决这类问题的另一种方法是将二元的遮罩转换成复合类型的目标,这是包括获胜方案等许多竞争选手采用的一种方法。U-Net 的一个优点是可以通过在最后一层使用 1*1 卷积来构建网络以实现任意多个输出来表示多个类型。
引用自 Data Science Bowl 获胜方案:
目标为 2 通道遮罩使用 sigmod 激活函数的网络,即(遮罩 - 边界,边界);目标为 3 通道遮罩使用 softmax 激活函数的网络,即(遮罩 - 边界,1 - 掩码 - 边界) 2 通道全遮罩,即(遮罩,边界)
在这些预测操作后,就可以使用传统的图像处理算法例如 watershed 做后处理进一步分割出单个细胞核。[14]

图 12. 视觉化分类:前景(绿色)轮廓(黄色)背景(黑色)
这是我第一次鼓起勇气参与 Kaggle 上官方举办的 CV 比赛,而且还是 Data Science Bowl。尽管我最后只以前 20% 的成绩完成了比赛(这通常是比赛的平均水准),但我还是很高兴地参与了这次 Data Science Bowl 并且学习到了一些实际参与和尝试才能学习到的东西。主动学习要远比观看和阅读在线课程资源有成效。
作为一名刚开始参与 Fast.ai 课程学习的深度学习从业人员,这是我漫长学习旅程的重要一步,也能从中获取宝贵的经验。所以,我建议各位可以特意地去尝试面对一些你从未见过或解决过的挑战,以感受学习未知事物的巨大乐趣。
我在这场比赛中学习到的另一个宝贵教训是,在计算机视觉(同样适用于 NLP)比赛中,亲眼检查每一个预测结果以判断哪些有效很重要。如果你的数据集足够小,那么应该检查每个输出。这可以让你进一步找到更好的思路,或在代码出问题时调试代码。
迁移学习以及其他
目前,我们已经讲解了原生 U-Net 的架构模块并如何转变目标以解决实例分割问题。现在我们来进一步的讨论这些类型编解码网络的灵活性。所谓灵活性,我是指在设计网络时能够拥有的自由度以及创新性。
迁移学习是个非常给力的想法,所以使用深度学习的人都避不开它。简单来说,迁移学习就是在缺乏大规模数据集时,使用在拥有大量数据的类似任务上预先训练好的网络。即使数据足够的情况下,迁移学习也能一定程度上提升性能,而且不仅可用于计算机视觉中,同时对 NLP 也有效。
迁移学习对类似 U-Net 的体系来说也是一种强力的技术。我们之前已经定义了 U-Net 中两个重要的组成部分:上采样和下采样。这里我们将它们理解为编码器和解码器。编码器接受输入并将其编码到一个低维特征空间,这就将输入用更低维度表征。那么试想如果用你理想的 ImageNet 替代这个编码器,比如: VGG, ResNet, Inception, NasNet 等任何你想要的。这些经过高度设计的网络都是在完成一件事:以尽可能优秀的方式对自然图像进行编码,并且 ImageNet 上可以在线获取它们的预训练权值模型。
因此,为什么不使用它们其中一种架构作为我们的编码器,再构建一个解码器,这将与原先的 U-Net 一样可用,但更好,更生猛。
TernausNet 是 KaggleVagle Carvana 挑战的获胜方案的网络架构,它就使用相同的思路,以 VGG11 作为编码器。[15、16]

Vladimir Iglovikov 和 Alexey Shvets 的 TernausNet
Fast.ai: 动态 U-Net
受到 TernausNet 论文以及其他许多优秀资料的启发,我将这个想法简述为,将预训练或预设的编码器应用于类似于 U-net 的架构。因此,我提出了一个通用体系结构:动态 U-Net。
动态 U-Net 就是这个想法的实现,它能够完成所有的计算和匹配,自动地为任何给定的编码器创建解码器。编码器既可以是现成的预训练的网络,也可以是自定义的网络体系结构。
它使用 PyTorch 编写,目前在 Fast.ai 库中。可以参考这个 文档 来查看实践样例或查看源码。动态 U-Net 的主要目标是节省开发时间,以实现用尽可能少的代码更简易地对不同的编码器进行实验。
在第 2 部分中,我将解释针对三维数据的编码器解码器模型,例如 MRI(核磁共振成像)扫描图像,并给出我一直在研究的现实案例。
参考文献
[5] Faster R-CNN: Towards Real-Time Object Detection with Region Proposal Networks: arxiv.org/abs/1506.01…
[6] Mask R-CNN: https://arxiv.org/abs/1703.06870
[7] Feature Pyramid Networks for Object Detection: https://arxiv.org/abs/1612.03144
[8] Fully Convolutional Networks for Semantic Segmentation: https://people.eecs.berkeley.edu/~jonlong/long_shelhamer_fcn.pdf
[9] U-net: Convolutional Networks for Biomedical Image Segmentation: https://arxiv.org/abs/1505.04597
[10] Tensorflow Mask-RCNN: https://github.com/matterport/Mask_RCNN
[11] Pytorch Mask-RCNN: https://github.com/multimodallearning/pytorch-mask-rcnn
[12] Convolution Arithmetic: https://github.com/vdumoulin/conv_arithmetic
[13] Data Science Bowl 2018 Winning Solution, ods-ai: https://www.kaggle.com/c/data-science-bowl-2018/discussion/54741
[14] Watershed Algorithm docs.opencv.org/3.3.1/d3/db…
[15] Carvana Image Masking Challenge: www.kaggle.com/c/carvana-i…
[16] TernausNet: U-Net with VGG11 Encoder Pre-Trained on ImageNet for Image Segmentation: https://arxiv.org/abs/1801.05746
感谢 Prince Grover 和 Serdar Ozsoy。
如果发现译文存在错误或其他需要改进的地方,欢迎到 掘金翻译计划 对译文进行修改并 PR,也可获得相应奖励积分。文章开头的 本文永久链接 即为本文在 GitHub 上的 MarkDown 链接。
掘金翻译计划 是一个翻译优质互联网技术文章的社区,文章来源为 掘金 上的英文分享文章。内容覆盖 Android、iOS、前端、后端、区块链、产品、设计、人工智能等领域,想要查看更多优质译文请持续关注 掘金翻译计划、官方微博、知乎专栏。